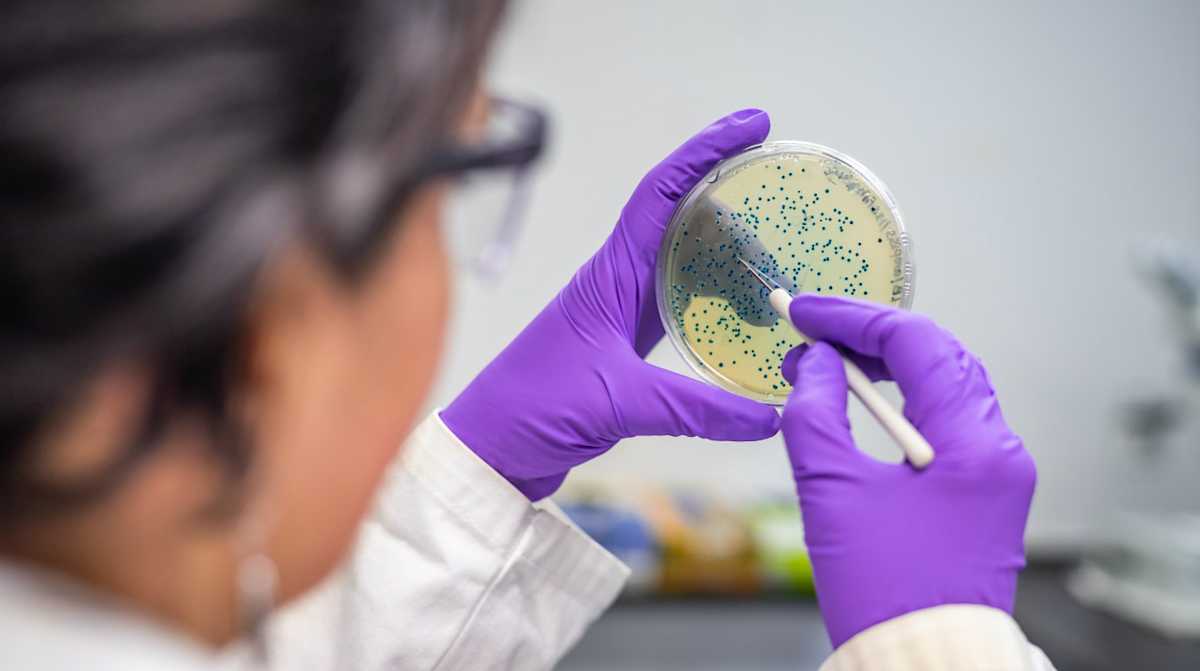

The Price Of Greatness Is Responsibility Meaning In Telugu

The price of greatness is responsibility meaning in telugu
Related post The price of greatness is responsibility meaning in telugu:
- thou shalt not make unto thee any graven image meaning
- thousand foot krutch courtesy call download
- those we love never truly leave us there are things that death cannot touch
- thousand foot krutch courtesy call download mp3
- those who make peaceful revolution impossible will make violent revolution inevitable meaning
- those were the days my friend movie
- thousand years christina perri free mp3 download
- those were the days my friend we thought they d never end song
Source : pinterest.com